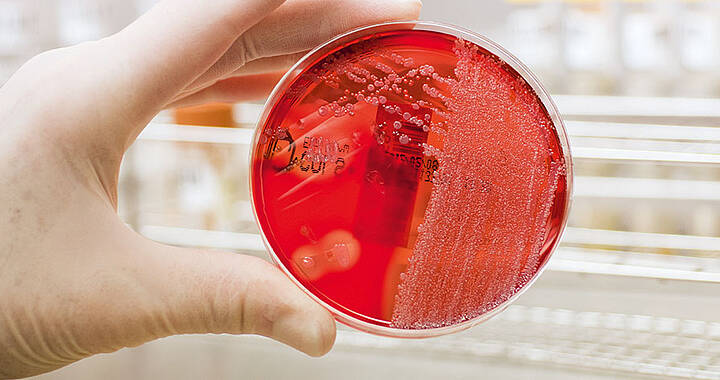

Leitung

Selin Temizel
Leitung der Stabsstelle
Oberärztin

Dr. Olivera Dzoic
Stellvertretende Leiterin der Stabsstelle
Oberärztin
Sekretariat


Katharina von Stetten
Teamassistenz
Telefon: 0821 400-164405
E-Mail: katharina.vonstetten@uk-augsburg.de